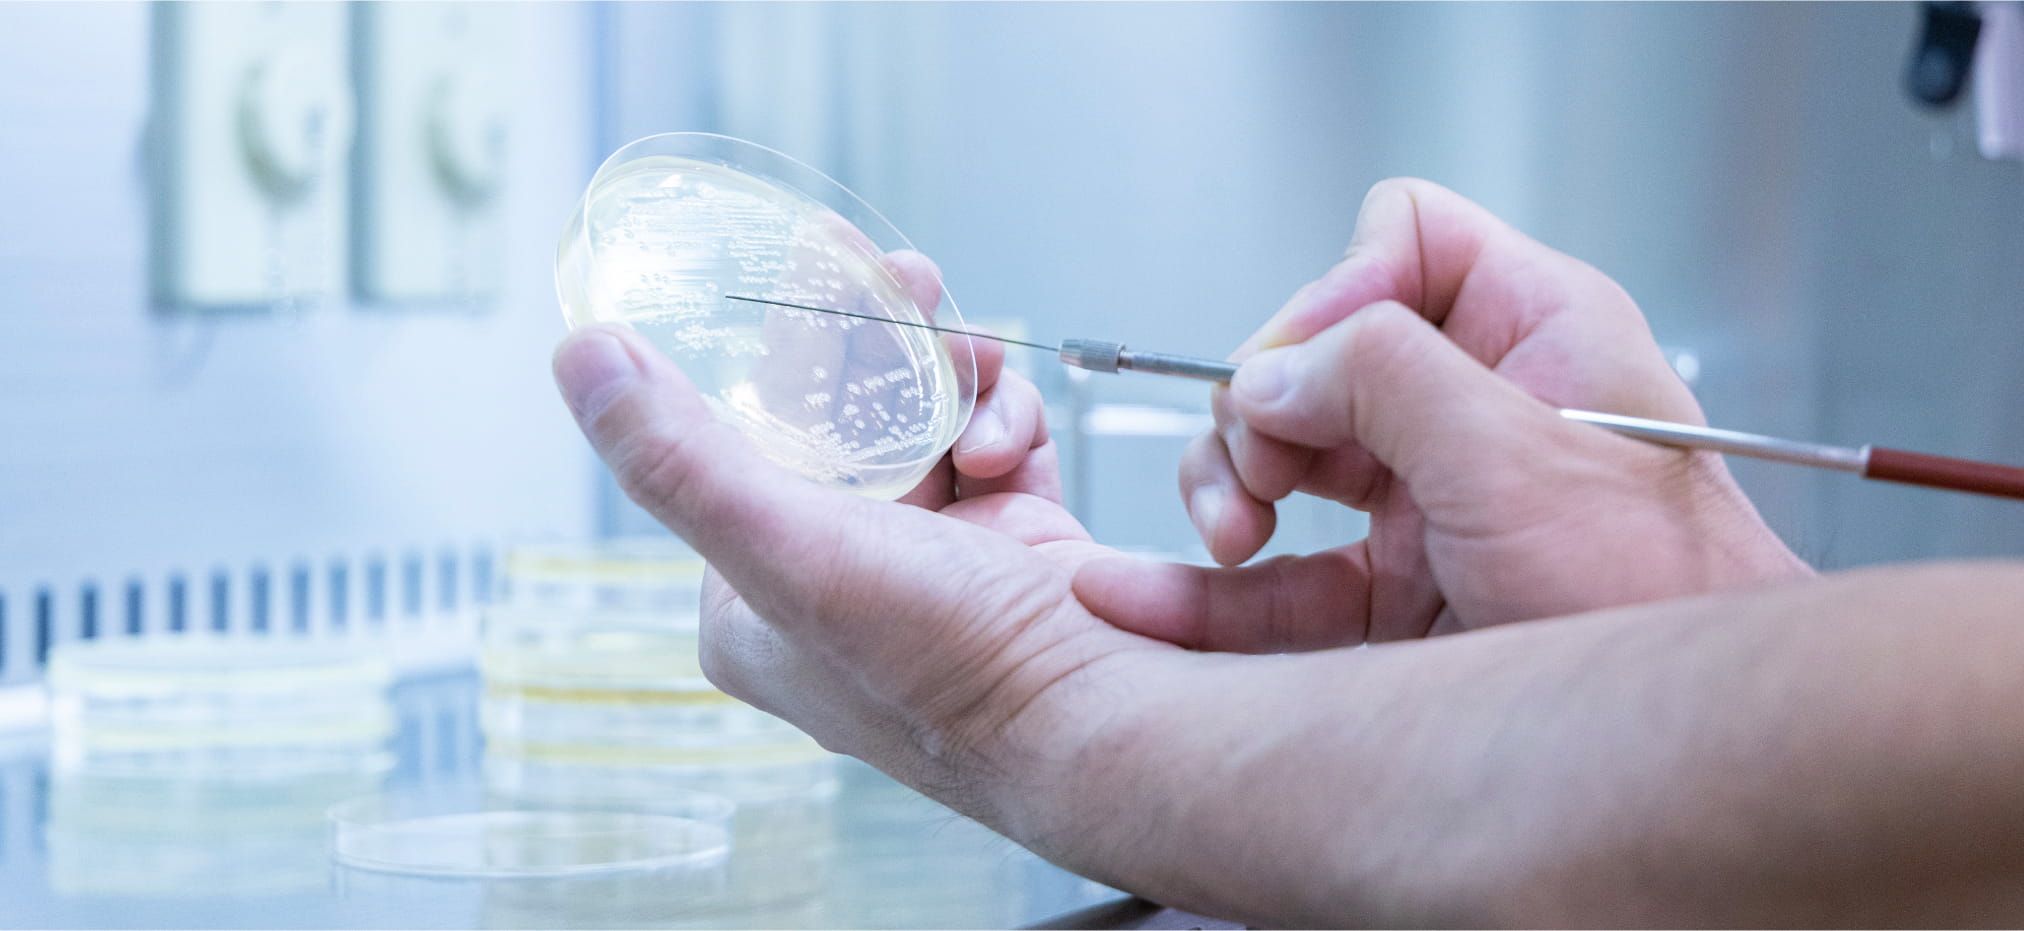

鳥由来感染症の制御を通しグローバルヘルスを実現する
鳥由来感染症
グローバルヘルス研究センター
について
About AIDGH
AIDGHは、高病原性鳥インフルエンザなど鳥類により
地球規模で拡大する感染症や抗菌薬耐性菌の実態解明や制御によるグローバルヘルス実現のため、
2025年度に全学組織として鳥取大学に設置されました。
AIDGHは、5つの研究部門
(疾病管理学研究部門、病態学研究部門、環境生態学研究部門、分子疫学研究部門および海外病研究部門)と
研究力強化戦略室で構成され、我が国唯一の鳥由来感染症専門研究機関として、
鳥インフルエンザなど鳥由来感染症の制御、鳥類における抗菌薬耐性菌の制御と人材育成、
これらを主要なプロジェクトとして掲げています。


Project
プロジェクトについて
本センターのプロジェクトについてご紹介します。